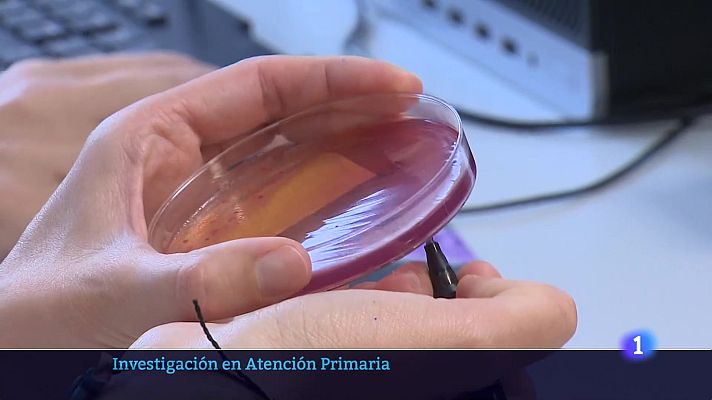
Informativo Telerioja - Informativo Telerioja 2 - 20-06-2025

Informativo Telerioja
Informativo Telerioja 2 - 20-06-2025
Informativo telerioja 2 - 20-06-2025
20/06/2025 00:09:57